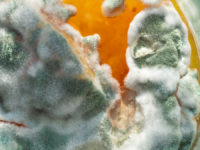

Hjärtspecialisten tipsar – Så håller du ditt hjärta friskt

Du har inte ont eller några större problem? Då borde din hälsa vara i bra skick eller hur? Den här uräkten använder vi oss ofta av för att slippa anstränga oss men vi kan nog alla komma överens om att det är bättre att förhindra sjukdom än att försöka bota den. Hjärtat är ett av […]
De här sakerna får du absolut inte spola ner i vasken

Det finns många saker vi vet att man absolut inte ska spola ner i vasken, till exempel målarfärg med lösningsmedel. Det finns dock en hel del som de flesta faktiskt inte har någon aning om att de inte ska låta åka ner i rören. I den här artikeln får du förhoppningsvis lära dig någonting nytt […]
Häll salt i din schampooflaska

Av alla konstiga tips och tricks som finns ute på nätet måste det här vara bland dem som är svårast att tro på. Varför ska man hälla salt i håret? Det kan faktiskt ha fördelar! Salt har använts i tusentals år både till hudvård och som hårvård och det som salt gör för håret är […]
Slipp gå upp och kissa på natten

Att behöva gå upp på nätterna för att kissa är hemskt. Speciellt den här perioden är det ofta kallt och har man otur vaknar man till så pass mycket att det är svårt att somna om sen. Det finns dock några smarta knep som gör att man kan slippa nattbesöken på toaletten! Till att börja […]
Håll bilnyckeln mot huvudet och hitta din bil enklare

Majoriteten av de moderna bilarna har idag ingen fysisk nyckel man låser upp bilen med utan en fjärrkontroll som du öppnar bilens centrallås med. Hur långt ifrån du kan låsa upp bilen skiljer sig från olika tillverkare och bilmodeller men genom att hålla nyckeln mot huvudet kan du faktiskt utöka räckvidden. Var och varannan gång […]
Hindra immiga glasögon när du har munskydd!

Vi är mitt inne i andravågen av corona och det ser ut att kunna bli lika illa, om inte värre, än i våras. Naturligt har munskydd blivit en vardag för många när de rör sig ute, med det har många tyvärr fått konstant immiga glasögon. Som tur är har vi lösningen! När du har på […]
Salt med eller utan jod?

Har du någon gång stått i mataffären och börjat fundera över skillnaderna mellan salt med jod eller utan jod? Förutom att det redan finns tusen sorters olika textur på salt i form av flingsalt, himalayasalt, finkortnigt salt etc. ska man alltså även ta ställning till innehållet. Om du inte riktigt är säker på huruvida salt […]
Skrynklig t-shirt? Så här får du den slät på någon sekund utan att använda ett strykjärn.

Det spelar ingen roll hur noga man viker in dem i garderoben, vissa t-shirtar skrynklar sig något otroligt oavsett. Speciellt de som är tillverkade i bomull. Det är inte alltid läge att plocka fram strykjärnet och strykbrädan för att få t-shirten slät. Ibland är det för att man har bråttom någonstans och ibland bara för […]
Vanliga missen som sprider miljontals bakterier i badrummet

Att hålla god hygien i badrummet är viktigt för de flesta av oss och därför brukar vi se till att städa noga minst en gång i veckan. Vissa bakterier är inte dåliga för oss utan vi behöver bakterier för att kunna överleva. Kiss- och bajsbakterier är dock någonting vi inte behöver och gärna inte vill […]
Ätit någonting mögligt? Så här farligt är det.
Alla har i alla fall minst en gång gjort ett par smörgåsar bara för att upptäcka några gröna prickar när man redan tryckt i sig halva mackan. Oftast blir man lite orolig, men är det verkligen så farligt? Svaret är nej, det är inte speciellt farligt att du borde bry dig något särskilt. Vi äter […]
Därför ska du hälla diskmedel i toaletten

Får du ofta stopp i toaletten? Lösningen för många brukar vara kemiskt starka lösningar man måste springa ner till affären för att får tag i. Det finns dock en enkel lösning med något du definitivt redan har hemma, nämligen diskmedel! Det kanske låter oväntat men diskmedel är ett precis lika bra lösningsmedel som vilken propplösare […]